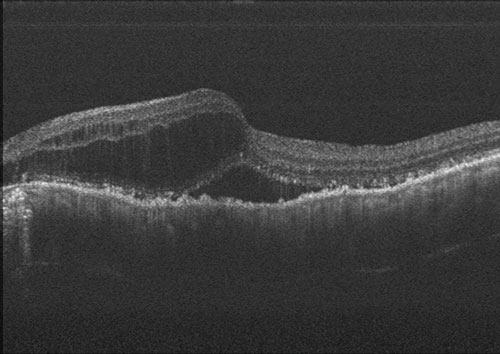

光干渉断層計 ACT100
NEW MODEL
● OCT ポータブル&ハンディ
● オートアライメント オートフォーカス 自動撮影
● Thickness-map 網膜/ONH/GCCL
浮腫
加齢黄斑変性
緑内障
黄斑円孔
ポータブル&ハンディに対応するOCT 様々なシーンにて活用できる柔軟な設計
OCT
軸方向分解能 10 um
横方向分解能 20 um
光源波長 840 nm
スキャン深度 ∼2 mm
スキャン範囲(最大)6*6 mm and 9*9 mm
被検眼視度補正範囲 +/-15 D
スキャンスピード 80,000A-Scan/Sec.
撮影可能最小瞳孔径 φ2.5 mm
スキャン画素 1024 x 512 pixels
Fundus Camera
解像度 500万画素
視野 45 度
撮影可能最小瞳孔径 4 mm
被験眼視度補正範囲 +/-15 D
インターフェース
HDMI
Wi-Fi
プローブ
L250 x W58 x H65 mm
Weight: 500 g
本体
L293 x W237 x H127 mm
Weight: 4.5 kg
アクセサリー
フットスイッチ・プローブ
ハンドル・アイカップ
- 認証番号:304AGBZI00008000